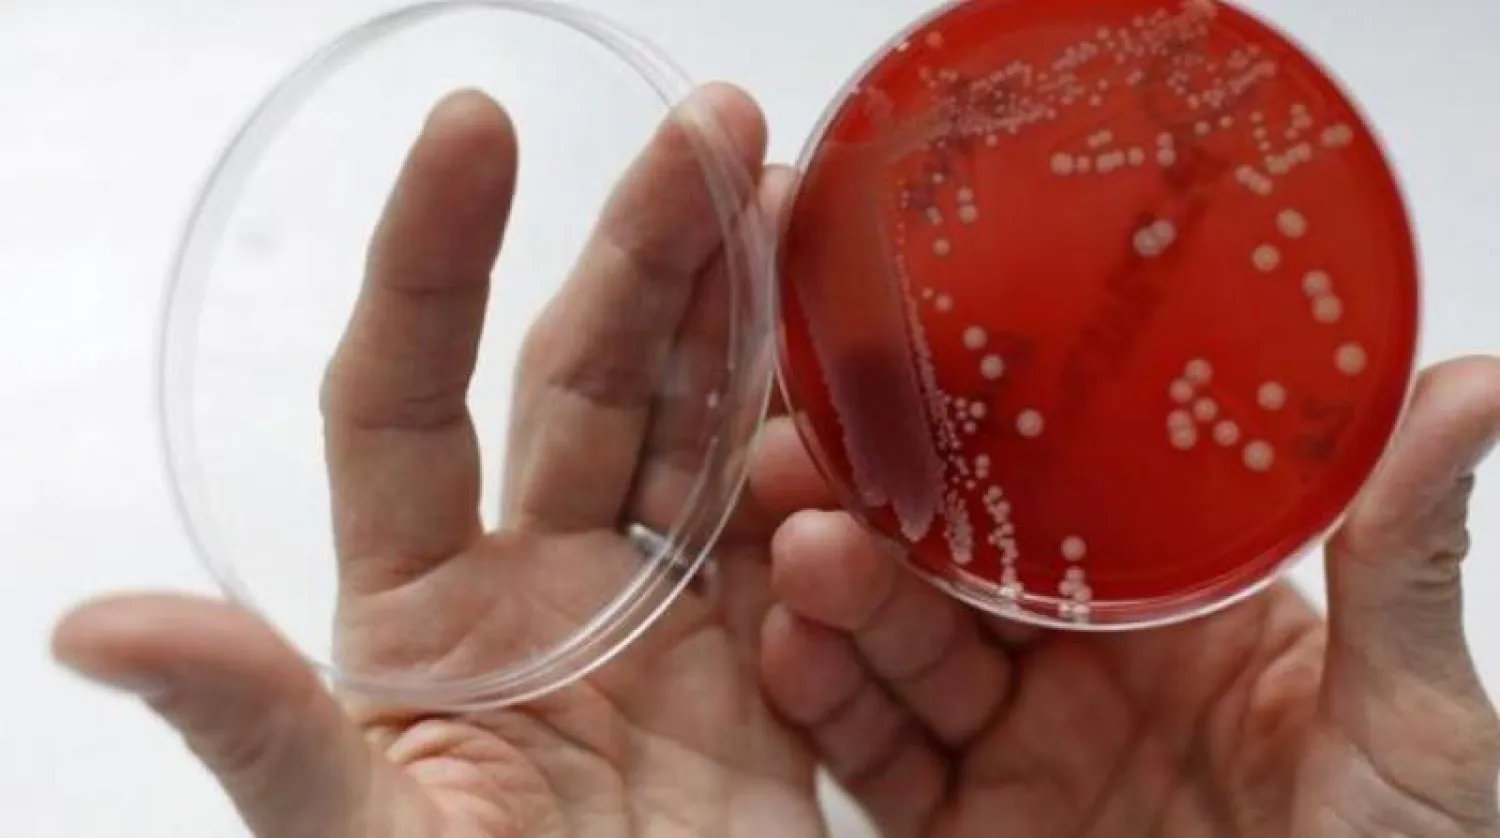
باحثون: مسببات الأمراض الفطرية تتكيف مع الاحتباس الحراري بشكل خطير!

أظهر باحثون كيف يمكن للفطريات المسببة للأمراض أن تتطور في مناخ دافئ لتحمّل بشكل أفضل الحرارة داخل أجسامنا.
وبالنظر إلى أن الحرارة هي التي تقوم بمعظم مهمة حمايتنا من هذه التهديدات، فإن المعنى الضمني هو أن هذه العوامل الممرضة قد تصبح خطرًا أكبر من حيث المرض لأنها تتكيف مع كوكب يزداد سخونة باستمرار.
وتقول عالمة الوراثة الجزيئية عالمة الأحياء المجهرية آسيا جوسا من كلية الطب بجامعة ديوك بنورث كارولينا «هذه ليست أمراضًا معدية بالمعنى الساري؛ فنحن لا ننقل الفطريات لبعضنا البعض. إننا نتنفس جراثيم الفطريات طوال الوقت وأن جهاز المناعة لدينا مجهز لمكافحتها».
فقد نظر فريق الدراسة الجديدة بالتفصيل في فطر ممرض يسمى «Cryptococcus deneoformans» ووضعه في ظروف معملية ورفع درجة حرارته من 30 درجة مئوية (86 درجة فهرنهايت) إلى 37 درجة مئوية (98.6 درجة فهرنهايت). وقد أدت هذه الضغوط الحرارية إلى تغيير المشهد الجيني للفطريات بشكل كبير، وفق موقع «ساينس إليرت» العلمي المتخصص نقلا عن PNAS.
وعلى وجه التحديد، كان هناك المزيد من الحركة بين «الجينات القافزة»؛ تلك العناصر القابلة للنقل داخل الحمض النووي التي يمكن أن تغير موضعها في الجينوم خمسة أضعاف الحركة عند درجة حرارة أعلى. وفي حين أن هذه العناصر القابلة للنقل لا تصنع البروتينات بشكل مباشر، إلا أنها يمكن أن تؤثر على طريقة عمل الجينات الأخرى.
وتم تعقب ثلاثة جينات قافزة على وجه الخصوص: T1 و Tcn12 و Cnl1، تشير التحولات التي أجراها الفريق داخل الجينات والجينوم إلى أنها قد تغير طريقة ترميز الجينات، وربما تؤدي إلى مقاومة الأدوية. فيما لا يزال من غير الواضح تمامًا النتيجة النهائية لهذا النشاط المتزايد.
وفي هذا الاطار، تم إجراء مزيد من الاختبارات على الفئران؛ حيث كان نشاط العناصر القابلة للنقل أكثر وضوحًا. لذلك يعتقد الباحثون أن وجود الحيوان في الواقع، مع استجابته المناعية وعمليات أخرى، قد يزيد من الحركة.
وتؤكد جوسا «لقد رأينا دليلًا على تعبئة جميع العناصر الثلاثة القابلة للنقل في جينوم الفطريات بغضون 10 أيام فقط من إصابة الفأر. من المحتمل أن تساهم هذه العناصر المتحركة في التكيف في البيئة وأثناء الإصابة. ويمكن أن يحدث هذا بشكل أسرع لأن الإجهاد الحراري يسرع من عدد الطفرات التي تحدث».
لم يحن الوقت بعد لبناء مخبأ تحت الأرض، إذ لا يزال البحث في مراحله الأولى ولا يشمل بشرًا حقيقيين. والأكثر من ذلك، أن الجراثيم الفطرية عمومًا أكبر من الفيروسات، لذا فإن الاحتياطات مثل أقنعة الوجه ستكون أكثر فعالية ضدها. لكن ما أظهره البحث هو أن زيادة الحرارة تؤدي إلى تغيرات جينية أسرع في «C. deneoformans». والخلاصة هي أن الفطريات الخطرة يمكن أن تتطور بسرعة أكبر مما كنا نظن مع ارتفاع درجات الحرارة في جميع أنحاء العالم.
أما المرحلة التالية فهي دراسة مسببات الأمراض من الأشخاص الذين أصيبوا بعدوى فطرية انتكاسية. حيث تقتل عدوى مثل هذه بالفعل مئات الآلاف من الأشخاص سنويًا، ولكن في الوقت الحالي لا يتعرض للخطر سوى الأشخاص الذين يعانون من ضعف شديد في المناعة. ويمكن أن يبدأ هذا في التغيير يومًا ما، وفق جوسا، التي تؤكد «هذا هو بالضبط نوع الشيء الذي أتحدث عنه. الأمراض الفطرية آخذة في الارتفاع، ويرجع ذلك إلى حد كبير لزيادة عدد الأشخاص الذين يعانون من ضعف في جهاز المناعة أو الظروف الصحية الأساسية».
10:32 دقيقه
باحثون: مسببات الأمراض الفطرية تتكيف مع الاحتباس الحراري بشكل خطير!
https://aawsat.com/home/article/4133856/%D8%A8%D8%A7%D8%AD%D8%AB%D9%88%D9%86-%D9%85%D8%B3%D8%A8%D8%A8%D8%A7%D8%AA-%D8%A7%D9%84%D8%A3%D9%85%D8%B1%D8%A7%D8%B6-%D8%A7%D9%84%D9%81%D8%B7%D8%B1%D9%8A%D8%A9-%D8%AA%D8%AA%D9%83%D9%8A%D9%81-%D9%85%D8%B9-%D8%A7%D9%84%D8%A7%D8%AD%D8%AA%D8%A8%D8%A7%D8%B3-%D8%A7%D9%84%D8%AD%D8%B1%D8%A7%D8%B1%D9%8A-%D8%A8%D8%B4%D9%83%D9%84-%D8%AE%D8%B7%D9%8A%D8%B1



باحثون: مسببات الأمراض الفطرية تتكيف مع الاحتباس الحراري بشكل خطير!


باحثون: مسببات الأمراض الفطرية تتكيف مع الاحتباس الحراري بشكل خطير!
مواضيع
مقالات ذات صلة
لم تشترك بعد
انشئ حساباً خاصاً بك لتحصل على أخبار مخصصة لك ولتتمتع بخاصية حفظ المقالات وتتلقى نشراتنا البريدية المتنوعة























